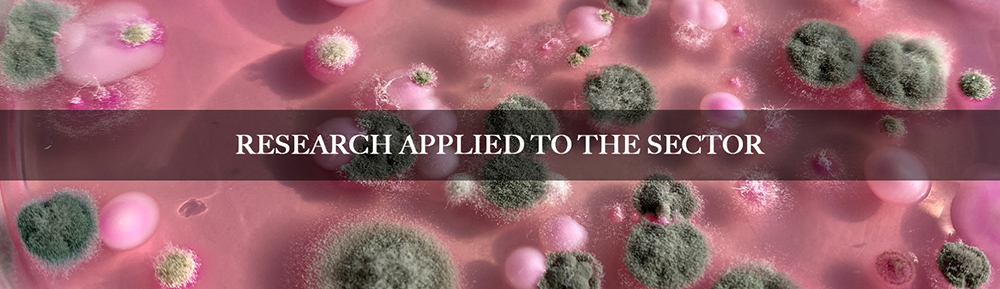

DAIRY CENTRE, TRAVEL COMPANION OF THE DAIRY SECTOR “Our milk, our producers, our health”
Dairy Centre promotes the comprehensive development of the dairy sector, acting as a driver of innovation and progress. By combining applied research, the development of innovative products, and the transfer of specialized knowledge, we provide an effective response to the challenges and needs of the sector. Under the slogan “Our milk, our producers, our health,” our goal is to work together to build a strong, sustainable, and competitive dairy sector. In recent years, the dairy sector of Basque Country has evolved significantly, moving away from artisanal production methods and demonstrating its ability to face new challenges.
The sector is mainly managed by family units, with more than 95% consisting of micro-dairies. Producers are responsible not only for milk production, but also for the processing stages that add value to the products and make them competitive in the market.
However, artisanal models present several challenges: limited economic resources, difficulty in implementing new technologies, difficulties in accessing technological knowledge and diversification, etc. In addition, strict health and hygiene regulations and the need to manage complex marketing processes have increased the need for external technological advice.
To address all these challenges and after 15 years of operation, ESNEKI ZENTROA was created as a brand in 2021, under the leadership of the Leartiker Technology Center, to keep responding to the needs of the sector. The objective of the Dairy Centre is to strengthen and serve as a benchmark for the dairy sector, combining research, innovation, and technical knowledge to promote the quality, safety, sustainability, and competitiveness of artisanal production.
At Dairy Centre, we work with a comprehensive approach, from improving milk quality to marketing dairy products and cheeses, intervening in all processes. We are traveling companions for dairy producers and cheese makers, from their foundation to the stabilization phase, providing knowledge and technical support in different areas.
In recent years, we have carried out important research in the field of food safety and milk and dairy product technology. The following are the different lines of research that can be highlighted (https://esnekizentroa.eus/en/projects/):
Research related to food safety:
We have developed various research projects related to microbiological and chemical risks associated with the safety of milk and dairy products, including:
SHIGA: genetic study of different Escherichia coli strains capable of producing Shiga toxin.
ELAMINA-2: Evaluation of different strategies for the elimination of biogenic amines present in cheeses that undergo high levels of proteolysis during processing and ripening.
EZtaphTox: Regulatory genes and triggering factors of enterotoxins production in S. aureus in food.
GAZTANOLA: Research aimed at obtaining applicable evidence in the application process for the use of wooden shelves for cheese ripening.
Research into the technological capacity of milk:
We research the microbiological and physicochemical characteristics of milk, analyzing its technological capacity for cheese production and adapting production processes with the aim of developing cheeses of differentiated quality. In recent years, the following projects, among others, have been developed in this area:
MILKSUIT: Adaptation of feeding and livestock management practices of milk production suitable for cheesemaking.
DAIRITAL: Development of sustainable production systems in the traditional dairy sector in the SUDOE area.
ESNEKAL: Study of the microbiological and protein quality of raw sheep’s and goat’s milk in order to prevent technological problems in cheese production.
PROTEBAL: Study of the protein fraction and native lactic flora of raw milk as a quality factor and classification for traditional cheese producers in the Basque Country.
Research into dairy and cheese-making technology and ripening techniques:
We develop projects that integrate research into the technological parameters that influence the production of dairy products, as well as the different ripening techniques applied to different families of cheeses, such as:
BEHITEK: Development of innovative cow’s milk cheeses of differentiated quality.
ONDTEK: Validation of the production process for hard sheep’s cheese by parameterizing the physicochemical reference values.
GAZTAKAL: Analysis of the technological parameters of the processing process of each cheese family as quality control of the processing and ripening process.
BLUECARE: Introduction of digital and sensor technologies for the control of production and maturing of a blue cheese with differentiated organoleptic quality that is safe, healthy and sustainable.
The results of the various projects have been transferred to sector stakeholders through different channels, including training sessions, technical advice and specialized documentation. This transfer process has enabled the research results to be put into practice with the aim of influencing the sector’s daily activities. Furthermore, research projects related to food safety have been developed in close collaboration with Elika foundation and the Basque Government’s Food Safety Board in order to provide an effective and coordinated response to the sector’s needs.
In addition to developing applied research to respond to the sector’s needs, we also work in other relevant areas with the aim of promoting the comprehensive development of the sector.

We help cheese makers in their day-to-day operations by providing ongoing advice on production processes, compliance with current health and hygiene regulations, and adaptation of labelling to consumer information regulations. Our service includes:
- Advice on setting up a new cheese factory: space design, equipment requirements, and liaison with the Department of Health.
- Adaptation and optimization of production processes.
- Identification of potential defects in cheese production and adjustments to avoid them.
- Food safety management.
- Development, implementation and annual monitoring of self-control plans.
- Definition of action plans following audits by the Department of Health.
- Analysis of milk, dairy products and surfaces, and interpretation of results.
- Advice on incidents and implementation of corrective measures.

We offer specialized training aimed at the dairy sector, designed to enhance producers’ technical skills and knowledge. Our training offer covers the following areas:
- Milk and dairy product quality
- An introduction to cheese-making technology
- Production of different fresh dairy products
- Production of different categories of cheese
- Cheese maturing (in collaboration with MONS Formation)
- Cheese marketing (in collaboration with MONS Formation)
- MONS Experience (in collaboration with MONS Formation)
The dairy sector faces numerous challenges, but also unique opportunities. Production based on the artisanal model provides differentiation and quality, and the sector’s players demonstrate their capacity for innovation and continuous improvement every day.
The Dairy Centre is here to support the sector as a technological partner in its development. Together, combining innovation, knowledge and quality, we will continue to build a strong, sustainable and competitive dairy sector.

